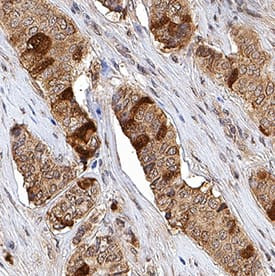
TK1 Antibody in Immunohistochemistry (Paraffin) (IHC (P))

Search
Invitrogen
TK1 Polyclonal Antibody
{{$productOrderCtrl.translations['antibody.pdp.commerceCard.promotion.promotions']}}
{{$productOrderCtrl.translations['antibody.pdp.commerceCard.promotion.viewpromo']}}
{{$productOrderCtrl.translations['antibody.pdp.commerceCard.promotion.promocode']}}: {{promo.promoCode}} {{promo.promoTitle}} {{promo.promoDescription}}. {{$productOrderCtrl.translations['antibody.pdp.commerceCard.promotion.learnmore']}}
产品信息
PA5-149466
种属反应
宿主/亚型
分类
类型
抗原
偶联物
形式
浓度
规格
纯化类型
保存液
内含物
保存条件
运输条件
RRID
产品详细信息
Reconstitute at 0.2 mg/mL in sterile PBS.
靶标信息
Thymidine Kinase (TK1) is a highly conserved phosphotransferase that is present in most living cells. Thymidine Kinase catalyzes the phosphorylation reaction: deoxythymidine + ATP = deoxythymidine 5'-phosphate + ADP; it is thus involved in the reaction chain to introduce deoxythymidine into the DNA. Thymidine kinase is required for the action of many antiviral drugs, such as azidothymidine (AZT), and is also used to select hybridoma cell lines in the production of monoclonal antibodies. Thymidine Kinase has many clinical applications as it is only present in anticipation of cell division.
仅用于科研。不用于诊断过程。未经明确授权不得转售。
篇参考文献 (0)
生物信息学
蛋白别名: cytosolic thymidine kinase; EC 2.7.1.21; epididymis secretory sperm binding protein; KITH; thymidine kinase (EC 2.7.1.21); Thymidine kinase, cytosolic; unnamed protein product
基因别名: TK1; TK2
UniProt ID: (Human) P04183
Entrez Gene ID: (Human) 7083